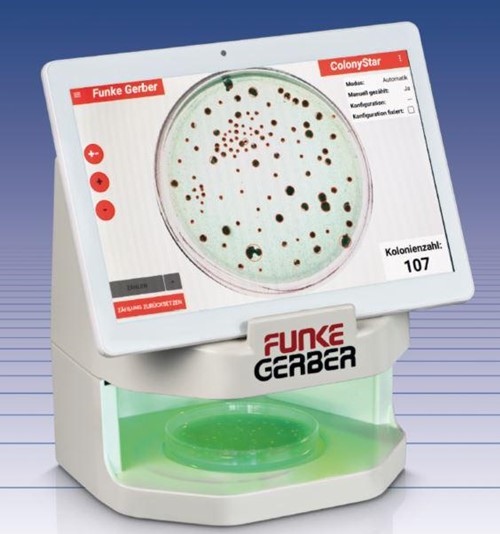

- Тесты на Антибиотики в молоке
- Тест на отпределение ингибирующих
- Лабораторное оборудование
- Центрифуги
- Индикаторные полоски
- Автоклавы
- Весы
- Термометры
- Упаковка
- АТФ-мониторинг PureTrust
- АТФ-мониторинг PIONEERPRODUKT CleanTrust
- Подложки MICROFAST®
- Питательные среды
- Палочки для мороженого
- Расходные материалы
- Моющие и дезинфицирующие средства
- Средство для обработки
- Фильтры для молока
- Салфетки
- Перчатки
- Отбор Проб
Власти Баварии во второй раз отменили Октоберфест из-за COVID-19
Фестиваль пива Октоберфест, который традиционно проходит осенью в Мюнхене, вновь не состоится из-за пандемии коронавируса. Об этом сообщили на пресс-конференции премьер-министр Баварии Маркус Зёдер и обер-бургомистр Мюнхена Дитер Райтер, передает Deutsche Welle.
Они объяснили это решение непредсказуемой ситуацией с covid-19 и назвали нереалистичным проведение фестиваля пива с соблюдением масочного режима и социальной дистанции между участниками.
Зёдер и Райтер добавили, что более поздняя отмена Октоберфеста нанесла бы еще больший экономический и имиджевый ущерб для организаторов.
Из-за коронавируса организаторы отменили проведение фестиваля Burning Man Общество
Фестиваль Октоберфест отменяют второй год подряд. В 2020 году правительство Баварии также отменило пивной фестиваль из-за угрозы распространения коронавируса.
 Экспресс-тесты для определения остаточного количества β-лактамов, тетрациклинов, хлорамфеникола, стрептомицинов в молоке, молочной сыворотке
Экспресс-тесты для определения остаточного количества β-лактамов, тетрациклинов, хлорамфеникола, стрептомицинов в молоке, молочной сыворотке Экспресс-тесты для определения остаточного количества фторхинолонов, эритромицина, линкомицина, тилозина и тилмикозина в молоке, молочной сыворотке
Экспресс-тесты для определения остаточного количества фторхинолонов, эритромицина, линкомицина, тилозина и тилмикозина в молоке, молочной сыворотке PIONEER MEIZHENG BIO-TECH (5 in 1) JC0726 /Экспресс-тесты для определения остаточного количества Бацитрацина, ансамицинов, клиндамицина, спирамицина, флорфеникола в молоке, молочной сыворотке
PIONEER MEIZHENG BIO-TECH (5 in 1) JC0726 /Экспресс-тесты для определения остаточного количества Бацитрацина, ансамицинов, клиндамицина, спирамицина, флорфеникола в молоке, молочной сыворотке Экспресс-тесты 4 в 1 для определения остаточного количества неомицина, канамицина, гентамицина, спектиномицина в молоке, молочной сыворотке
Экспресс-тесты 4 в 1 для определения остаточного количества неомицина, канамицина, гентамицина, спектиномицина в молоке, молочной сыворотке PIONEER MEIZHENG BIO-TECH (5 in1) JC0586 - Тесты на антибиотики 5 в 1 / Экспресс-тесты для определения остаточного количества β-лактамов, тетрациклинов и цефалексина в молоке, молочной сыворотке
PIONEER MEIZHENG BIO-TECH (5 in1) JC0586 - Тесты на антибиотики 5 в 1 / Экспресс-тесты для определения остаточного количества β-лактамов, тетрациклинов и цефалексина в молоке, молочной сыворотке PIONEER MEIZHENG BIO-TECH (5 in1) JC0871/ Экспресс-тесты для определения остаточного количества β-лактамов, тетрациклинов, хлорамфеникола, стрептомицинов, цефтиофура в молоке, молочной сыворотке.
PIONEER MEIZHENG BIO-TECH (5 in1) JC0871/ Экспресс-тесты для определения остаточного количества β-лактамов, тетрациклинов, хлорамфеникола, стрептомицинов, цефтиофура в молоке, молочной сыворотке.- ТЕСТЫ НА АНТИБИОТИКИ / МЕТОДОМ ИФА
- Экспресс-тесты PIONER 5 в 1 для определения сульфаниламидов, тилозина, тилмикозина, линкомицина, эритромицина, фторхинолонов
- Экспресс-тесты для определения остаточного количества тетрациклинов в мясе
- Экспресс-тесты для определения остаточного количества хлорамфеникола в мясе
Счетчик колоний микроорганизмов ColonyStar automatic
Счетчик колоний микроорганизмов ColonyStar automatic Термогигрометр ИВА-6АР (Россия)
Термогигрометр ИВА-6АР (Россия) Индикаторные полоски рН 5-9, 100 шт
Индикаторные полоски рН 5-9, 100 шт Индикаторные полоски “Белок”, 100 шт
Индикаторные полоски “Белок”, 100 шт Плита нагревательная Таглер ПН-4030СК
Плита нагревательная Таглер ПН-4030СК Стол мойка БА-CL- Х.Х МО С (одна чаша)
Стол мойка БА-CL- Х.Х МО С (одна чаша)- Прибор для определения чистоты молока «ОЧМ-М»
- Измеритель рН/температуры Testo 205 (Германия)
- Печь муфельная SNOL 8,2/1100 (8,2 л., камера – волокно)
- Бутирометры для молока, сливок, обезжиренного молока и пахты
- Индикаторные полоски “НС-Хлор”, 25 шт.
- Термогигрометр Testo 625
- Мешалка магнитная с функцией подогрева WH240-HT
- Аквадистилляторы электрические со встроенным сборником Liston
- Мешалка верхнеприводная WB2000-M
 Бумага для прямой упаковки KH PACK®
Бумага для прямой упаковки KH PACK® Кашированная Фольга
Кашированная Фольга Крышка
Крышка Бумага упаковочная крепированная противокоррозионная УНИК 14-70 ТУ 5453-003-05773103-2005
Бумага упаковочная крепированная противокоррозионная УНИК 14-70 ТУ 5453-003-05773103-2005 Бумага для ламинирования KH PACK®
Бумага для ламинирования KH PACK® Палочка для мороженого
Палочка для мороженого- Бумага для кaширования KH PACK®
- Коррексы для десертов
- Бумага для тарталеток KH PACK®
- Бумага для микрогофры
- Пластиковая упаковка для тортов и пирожных
- Силиконизированная бумага для производства средств гигиены
- Мешки бумажные
- Коррексы для салатов
- Бумага для изготовления пакетов KH PACK®
 Вспомогательные вещества для сахарной продукции
Вспомогательные вещества для сахарной продукции Палочки для мороженого (с логотипом)
Палочки для мороженого (с логотипом) Палочки для мороженого Магнум (фигурные)
Палочки для мороженого Магнум (фигурные) Палочки для мороженого Стандарт 114
Палочки для мороженого Стандарт 114 Пепсин свиной сывороточный
Пепсин свиной сывороточный Среды общего назначения НПЦ «Биокомпас-С» (г. Углич)
Среды общего назначения НПЦ «Биокомпас-С» (г. Углич)- Палочки для мороженого Стандарт 93
- Чашка Петри 90 мм
- Вафельный стаканчик и конус
- Технология J-Bottom
- Палочки для мороженого (круглые)
 Щелочное моющее средство (20л / 24кг)
Щелочное моющее средство (20л / 24кг) Повал с петлей для КРС
Повал с петлей для КРС Соска запасная
Соска запасная Средство для обработки вымени перед доением (20 л)
Средство для обработки вымени перед доением (20 л) Мыло жидкое «Prestige» (желтое, зеленое, красное) 5 л
Мыло жидкое «Prestige» (желтое, зеленое, красное) 5 л Средство дезинфицирующее с моющим эффектом (10кг)
Средство дезинфицирующее с моющим эффектом (10кг)- Насос для искусственной вентиляции лёгких
- Дозировочный шприц, насадка под флакон
- Средство для обработки вымени после доения (20 л)
- Перчатки из латекса (удлинённая манжета с валиком), (цвет синий, упаковка 50 штук)
- Кольца против Самовыдаивания
- Иглы Ветеринарные Многоразовые
- Дренчер для выпойки телят с гибким зондом
- Пеновой стакан для обработки вымени
- Ванна для копыт
 MicroFast® Lactic Acid Bacteria Count Plate Подложка для определения Молочнокислых микроорганизмов ( каталожный номер LR1312)
MicroFast® Lactic Acid Bacteria Count Plate Подложка для определения Молочнокислых микроорганизмов ( каталожный номер LR1312) MicroFast® Environmental Listeria Count Plate Подложка для определения количества листерий в образцах окружения (каталожный номер LR1008)
MicroFast® Environmental Listeria Count Plate Подложка для определения количества листерий в образцах окружения (каталожный номер LR1008) MicroFast® Staphyloccocus aureus Confirmation Plate Диски для подтверждения Staph.aureus (каталожный номер LR1005Q)
MicroFast® Staphyloccocus aureus Confirmation Plate Диски для подтверждения Staph.aureus (каталожный номер LR1005Q) Подложка для определения количества колиформных бактерий (каталожный номер LR1002) MicroFast® Coliform Count Plate
Подложка для определения количества колиформных бактерий (каталожный номер LR1002) MicroFast® Coliform Count Plate Подложка для определения количества дрожжей и плесневых грибов (каталожный номер LR1003) MicroFast® Yeast & Mold Count Plate
Подложка для определения количества дрожжей и плесневых грибов (каталожный номер LR1003) MicroFast® Yeast & Mold Count Plate Микробиологические подложки MicroFast®
Микробиологические подложки MicroFast®- MicroFast® Bacillus cereus Count Plate, Подложка для определения Bacillus cereus (каталожный номер LR1010)
- Подложка для ускоренного определения КМАФАнМ, (каталожный номер LR1321)
- Подложка для определения кол-ва стафилококков (Каталожный номер LR1005) MicroFast® Staphyloccocus aureus Count Plate
- MicroFast® Enterobacteriaceae Count Plate Подложка для определения количества энтеробактерий (каталожный номер LR1011)
- Подложка для определения КМАФАнМ (каталожный номер LR1001)
- MicroFast® Salmonella Count Plate (SAL), Подложка для определения количества сальмонеллы в образцах продуктов и окружения (каталожный номер LR1006)
- MicroFast® Coliform & E.coli Count Plate Подложка для определения количества E.coli и колиформных бактерий (каталожный номер LR1007)
 Лукашенко высказался против простых решений по Витебской области и действий по пути наименьшего сопротивления 25.10.2025
Лукашенко высказался против простых решений по Витебской области и действий по пути наименьшего сопротивления 25.10.2025 Производство молока, инвестиции. Какие точки роста на пятилетку видит руководство Витебской области25.10.2025
Производство молока, инвестиции. Какие точки роста на пятилетку видит руководство Витебской области25.10.2025 Первичная задача - дойти до каждого сельхозпредприятия. Депутат о развитии АПК Витебской области25.10.2025
Первичная задача - дойти до каждого сельхозпредприятия. Депутат о развитии АПК Витебской области25.10.2025- Совместные проекты и обмен опытом. В каких направлениях Беларусь и Казахстан готовы развивать сотрудничество в АПК 24.10.2025
- Беларусь и Алтайский край намерены увеличить биржевую торговлю сельхозпродукцией24.10.2025
- Минск и Алжир готовят переговоры на высшем уровне. Почему Беларусь нацелилась на Север Африки?24.10.2025
- "Планы амбициозные". Брестский облисполком о вкладе региона в продбезопасность СГ 23.10.2025
- Указ: облисполкомам предоставлено право формировать сельскохозяйственные сырьевые зоны23.10.2025
- Новая мера поддержки АПК. В Минсельхозпроде разъяснили новации законодательства23.10.2025
- Признание заслуг и преданность делу. В Минске вручили госнаграды представителям различных сфер23.10.2025
- Белорусская делегация провела в Кампале переговоры с коллегами из Уганды, Ирана и Индии17.10.2025
- Азербайджан вошел в тройку крупнейших покупателей лесопродукции на БУТБ17.10.2025
- Новые продукты и рост объемов. Минсельхозпрод о стратегии развития молочной отрасли до 2035 года17.10.2025
- Минсельхозпрод: Беларусь прирастает в производстве молока16.10.2025
- Посол: белорусский экспорт продуктов питания в Казахстан значительно возрос16.10.2025
- Белорусские товары составляют 94% российского импорта молочной продукции16.10.2025
 Сокращение супермаркетов и гипермаркетов в России продолжается: эксперты говорят о новой волне ритейла25.10.2025
Сокращение супермаркетов и гипермаркетов в России продолжается: эксперты говорят о новой волне ритейла25.10.2025 Парагвай: Экспорт субпродуктов является растущей отраслью и уже достиг 95,4 млн долларов США25.10.2025
Парагвай: Экспорт субпродуктов является растущей отраслью и уже достиг 95,4 млн долларов США25.10.2025 Китай увеличил производство свинины на 7% в третьем квартале года25.10.2025
Китай увеличил производство свинины на 7% в третьем квартале года25.10.2025- Новые горизонты сотрудничества: Россия и Аргентина обсуждают совместный доступ на рынки продукции животного происхождения25.10.2025
- Птицефабрика «Третьяковская» в Воронежской области удвоит производство яиц на 2 миллиарда рублей25.10.2025
- «Индилайт» провел гастрономический мастер-класс с Сильвеной Роу, популяризируя индейку как полезный продукт25.10.2025
- Министерство сельского хозяйства США представило план по снижению цен на говядину25.10.2025
- С января по июль экспорт свинины из ЕС вырос на 1,6%25.10.2025
- Рост цен на мясо в Самаре: говядина достигла 750 рублей за килограмм25.10.2025
- Московская область планирует нарастить мясное производство на 25% к 2030 году25.10.2025
- Производство мяса птицы в Омской области выросло на 75% за 9 месяцев 2025 года25.10.2025
- Цены на мясные продукты в России продолжают расти: анализ причин и прогнозы25.10.2025
- Нарушения качества продукции выявлены на заводе «Правильные продукты»23.10.2025
- Нальчикский мясокомбинат выставил дебиторскую задолженность на торги23.10.2025
- Модернизация птицеводства в Нижегородской области: новые возможности и рост производства23.10.2025
- Рост яйценоскости кур-несушек в Кабардино-Балкарии: успехи и перспективы23.10.2025
 10 причин взять депозит04.05.2025
10 причин взять депозит04.05.2025 NYT увидела в санкциях Трампа новый уровень экономической войны США25.10.2025
NYT увидела в санкциях Трампа новый уровень экономической войны США25.10.2025 В Кремле пообещали ответ на санкции сообразно интересам России25.10.2025
В Кремле пообещали ответ на санкции сообразно интересам России25.10.2025- Захарова пообещала «жесткие шаги» в ответ на 19-й пакет санкций ЕС25.10.2025
- США ввели санкции против президента Колумбии25.10.2025
- Чего ожидать от «одной из самых рискованных» поездок Трампа25.10.2025
- Каллас рассказала о радости ЕС из-за новых санкций США против России24.10.2025
- Постпредство России назвало санкции ЕС «сизифовым трудом»24.10.2025
- Путин оценил новые санкции США24.10.2025
- Путин вспомнил, когда Трамп ввел наибольшее число санкций против России24.10.2025
- Белый дом заявил о надежде на то, что новые санкции нанесут вред России24.10.2025
- ЕС ввел санкции против помощника Медведева и ректора ВШЭ23.10.2025
- Politico узнал о расколе в ЕС из-за нового кредита Украине на €140 млрд23.10.2025
- Евросоюз запретил ввозить в Россию игрушки с моторчиком23.10.2025
- В РСТ разъяснили, что санкции ЕС не затронут российский туризм23.10.2025
- АвтоВАЗ и «Полюс» включили в 19-й пакет санкций ЕС против России23.10.2025
 В Британии предупредили о риске для миллионов из-за супербактерий06.01.2025
В Британии предупредили о риске для миллионов из-за супербактерий06.01.2025 Суд в Москве встал на сторону индийской компании в споре с Минздравом26.11.2024
Суд в Москве встал на сторону индийской компании в споре с Минздравом26.11.2024 Ученые оценили рост смертности из-за устойчивых к лекарствам бактерий29.10.2024
Ученые оценили рост смертности из-за устойчивых к лекарствам бактерий29.10.2024- В доме отравившейся семьи нашли антибиотик для скота и пестициды29.10.2024
- «Известия» сообщили о нехватке широко применяемых антибиотиков в России29.10.2024
- Минздрав назвал недостоверными данные о нехватке антибиотиков29.10.2024
- Ученые предупредили об угрозе возвращения допенициллиновых времен29.10.2024
- В Минздраве рассказали, как менялось отношение к антибиотикам в пандемию07.05.2024
- ВОЗ объяснила риски приема антибиотиков «на всякий случай»06.05.2024
- Врачи напомнили о порочной практике после решения властей по антибиотикам25.04.2024
- Минздрав убрал антибиотики и гормоны из стандарта лечения ОРВИ25.04.2024
- Антибиотики в масле: миф или реальность?06.03.2024
- Антибиотики в сметане: миф или реальность?05.03.2024
- Антибиотики в козьем молоке: влияние, проблемы и меры контроля16.02.2024
- Японцы прекратят выпуск в России популярного антибиотика вильпрафен23.12.2023
- Антибиотики в Молоке21.12.2023
 Антибиотики в минтае25.02.2024
Антибиотики в минтае25.02.2024 Антибиотики в селедке: миф или реальность?12.02.2024
Антибиотики в селедке: миф или реальность?12.02.2024 Антибиотики в окуне10.02.2024
Антибиотики в окуне10.02.2024- Антибиотики в кильке: факты и мифы10.02.2024
- Антибиотики в тунце: важная проблема здоровья и экологии09.02.2024
- Антибиотики в мясе30.01.2024
- Антибиотики в чебуреках: миф или реальность?29.01.2024
- Антибиотики в котлетах: проблема или миф?18.01.2024
- Антибиотики в Курице: Где Сосредоточена Высшая Концентрация?17.01.2024
- Антибиотики в карпе17.01.2024
- Где в Курице Больше Антибиотиков: Реальность и Предостережения16.01.2024
- Антибиотики в Лососе: Безопасность и Качество Продукта16.01.2024
- Антибиотики в Индейке15.01.2024
- Антибиотики в Сале: Реальность и Вопросы Безопасности15.01.2024
- Антибиотики в Жареных Пельменях: Факты, Риски и Как Обеспечить Безопасность15.01.2024
- Антибиотики в сосисках14.01.2024
 Антибиотики в кофе: мифы и реальность03.05.2025
Антибиотики в кофе: мифы и реальность03.05.2025 Вилы кованые: 10 интересных фактов16.05.2024
Вилы кованые: 10 интересных фактов16.05.2024 Бассейн и похудение: 10 интересных фактов10.03.2024
Бассейн и похудение: 10 интересных фактов10.03.2024- Тесты на антибиотики в молоке - 10 интересных фактов07.03.2024
- Чистим чайник от накипи, 10 интересных фактов...06.03.2024
- Антибиотики в пиве: 10 интересных фактов04.03.2024
- Дикий кабан, как выжить...01.03.2024
- Гнойны мастит, 10 инстересных фактов27.02.2024
- Лимон и алкоголь: 10 интересных фактов25.02.2024
- Мята - 10 интересных фактов25.02.2024
- Дикий кабан, 10 интересных фактов20.02.2024
- Дикий кабан и домашняя свинья: сравнение и преимущества20.02.2024
- Творог, 10 интересных фактов20.02.2024
- 10 Интересных фактов о молоке19.02.2024
- Как очистить унитаз - 10 интересных фактов (Кислота против щелочи)18.02.2024
- Козье молоко: 10 интересных фактов16.02.2024
 Дикроцелиоз у КРС09.03.2024
Дикроцелиоз у КРС09.03.2024 Демодекоз у КРС01.03.2024
Демодекоз у КРС01.03.2024 Гнойный мастит КРС27.02.2024
Гнойный мастит КРС27.02.2024- Гиподерматоз у КРС20.02.2024
- Гемонхоз у КРС11.02.2024
- Бурситы у КРС30.01.2024
- Бруцеллез у КРС29.01.2024
- Бронхопневмония у телят27.01.2024
- Бронхит у КРС26.01.2024
- Болезнь Мортелларо у КРС24.01.2024
- Беломышечная болезнь у КРС23.01.2024
- Бабезиоз КРС22.01.2024
- Ацидоз КРС20.01.2024
- Артрит у КРС20.01.2024
- Анаплазмоз у КРС18.01.2024
 Антибиотики при кашле: когда они необходимы и когда нет11.02.2024
Антибиотики при кашле: когда они необходимы и когда нет11.02.2024 В Минтруда напомнили об основных мерах безопасности во время проведения республиканского субботника 25.10.2025
В Минтруда напомнили об основных мерах безопасности во время проведения республиканского субботника 25.10.2025 В Минске бесправник на BMW не справился с управлением и врезался в столб25.10.2025
В Минске бесправник на BMW не справился с управлением и врезался в столб25.10.2025- В Вилейском районе правоохранители застали самогонщиков с поличным: выявлено 11 тыс. литров браги25.10.2025
- Забрал пенсию и кормил раз в 2-3 дня. В Витебске сын довел мать-инвалида до истощения25.10.2025
- В Беларуси с начала года в авариях пострадали 340 детей24.10.2025
- МВД: реальные истории осужденных сверстников - эффективная профилактика преступлений подростков 24.10.2025
- Минчанин осужден за истязание беременной сожительницы24.10.2025
- Пьяный житель Пинска угнал легковушку и повредил припаркованные автомобили23.10.2025
- В Беларуси с 25 октября по 2 ноября пройдет акция МЧС "За безопасность вместе"23.10.2025
- В этом купальном сезоне в Беларуси утонули 44 рыбака, 25 из которых были пьяными 23.10.2025
- В Бобруйске пьяный подросток угнал автомобиль 23.10.2025
- "Дом без пожара": спасатели проверяют жилье в Горецком районе 23.10.2025
- Она еще будет вам сниться! Белоруска побывала в Карелии, и вот что рассказала18.10.2025
- Успели "поработать" меньше месяца. Молодую пару наркокурьеров из Мозыря заключили под стражу18.10.2025
- Десять промилле: в Волковыске мужчина умер от острого отравления алкоголем18.10.2025
Персоны
Наши Партнеры
Топ 10 Предприятий
Тесты на Антибиотики в Молоке
- Экспресс-тесты для определения остаточного количества β-лактамов, тетрациклинов, хлорамфеникола, стрептомицинов в молоке, молочной сыворотке
- ТЕСТ-НАБОР для определения ингибирующих PIONEERPRODUKT® DASH-TEST, WC0040
- PIONEER MEIZHENG BIO-TECH (5 in1) JC0586 - Тесты на антибиотики 5 в 1 / Экспресс-тесты для определения остаточного количества β-лактамов, тетрациклинов и цефалексина в молоке, молочной сыворотке
- PIONEER MEIZHENG BIO-TECH (5 in1) JC0871/ Экспресс-тесты для определения остаточного количества β-лактамов, тетрациклинов, хлорамфеникола, стрептомицинов, цефтиофура в молоке, молочной сыворотке.
- PIONEER MEIZHENG BIO-TECH (5 in1) JC1165 / Экспресс-тесты для определения остаточного количества галофугинона, флавомицина, новобиоцина, флуниксина, дексаметазона/преднизолона в молоке, молочной сыворотке
